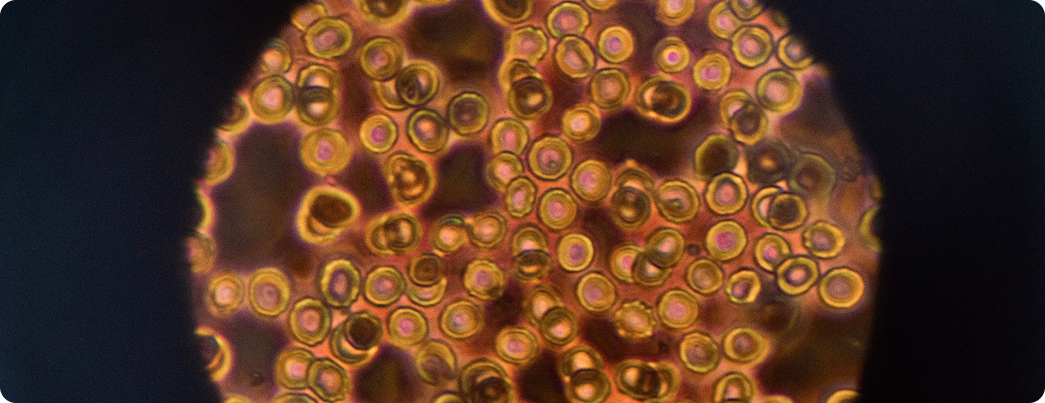

FrequenCell uses tailored electromagnetic frequencies to help align your body’s natural energy patterns, promoting cell communication and regeneration.
The human body is not a linear machine driven by chemical energy, but rather an open, system that strives to self-optimize within its wider biological, biochemical and biophysical ecosystem. In scientific terms, this ongoing process is referred to as autopoiesis and it refers to the natural tendency for biological systems to repair and regenerate in response to internal and external cues and stressors. The ability of biological systems to have achieve dynamic equilibrium in the face of changing environments is also known as homeostasis.
Cells are constantly renewing, repairing, and adapting themselves in response to environmental challenges and stimuli. The human body continuously adjusts, reorganises and optimizes itself, adapting to stressors and restoring balance without the need for external control—provided the biological framework is intact and the energetic environment sufficiently coherent.
Modern science now recognizes that both organic and inorganic matter, as well as all living cells and organisms, emit subtle energy fields—fields that influence how our bodies regulate chemistry, cellular communication, and biological functions.
FrequenCell products function in the quantum field and interact with our bodies’ natural signals to support balance, recovery, reorganization and overall wellbeing.
These cell types differ in structure, function, and genetic activity. Important types of cell include:
- Epithelial cells – e.g., skin and mucosal cells
- Organ cells – e.g., cells of heart, brain, liver, kidneys
- Muscle cells – smooth, skeletal (striated), and cardiac muscle cells
- Nerve cells (neurons) – for transmitting information
- Connective tissue cells – e.g., fibroblasts, fat cells
- Blood cells – red blood cells, white blood cells, platelets
- Immune cells – e.g., T cells, B cells, macrophages, natural killer cells
- Bone cells – osteoblasts, osteocytes, osteoclasts
- Stem cells – which can develop into other cell types
- Germ cells – sperm and egg cells
Electromagnetic fields can control or influence chemical and bioelectric reactions by:
Modifying molecular motion and orientation
Modulating electronic energy states
Influencing radical processes
Triggering light-driven reactions
Generating controlled heating
Reducing entropy
Our research
FrequenCell is committed to research that helps deepen our understanding and ability to apply frequency-based solutions in the wellbeing and healthcare spaces.
We are engaged in an ambitious program of research, with several laboratory and clinical trials, as well as practice-based research, already complete or underway, and additional research planned.
Explore some of our research below
Knee pain relief & mobility
Our latest clinical trial shows statistically significant pain relief and functional recovery for individuals with knee pain. The results highlighted reduced pain, improved mobility, and enhanced quality of life, demonstrating the effectiveness of frequency-based solutions.
CLINICAL TRIAL
Find out moreMenstrual pain
The results show that over two-thirds of participants no longer experience lower abdominal pain or breast tenderness, more than half report clearer skin, 30% are free of headaches, two-thirds have reduced cravings, and 10% have changed their eating habits.
PRE CLINICAL TRIAL
Find out moreLab Tests Metabolism of Cells
Cell Regeneration Lab results from German cell biologists show a 25% increase in cell regeneration and a 60% boost in metabolism.
LAB TEST
Find out moreCell Test
The study published in the Japan Journal of Medicine indicates a 23% increase in neutrophil metabolism, enhancing immune defense.
LAB TEST
Find out more
"With the various CELLs, I achieve excellent results with my patients. I use them frequently for both sudden and long-lasting issues, even beyond my own field of specialization. The results I see continually impress me. These frequency wearables have become an integral part of my international practice group."


